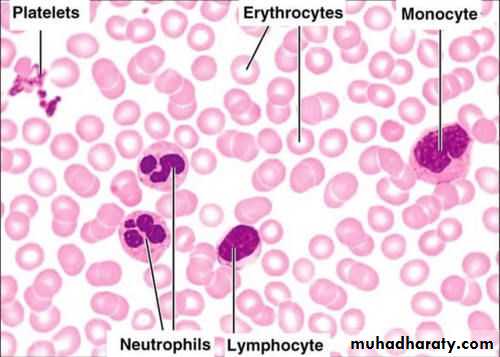
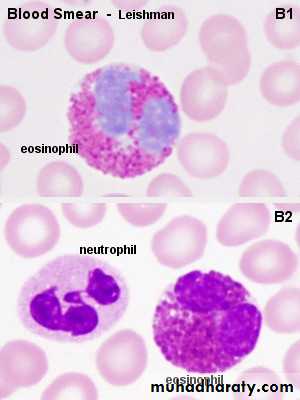
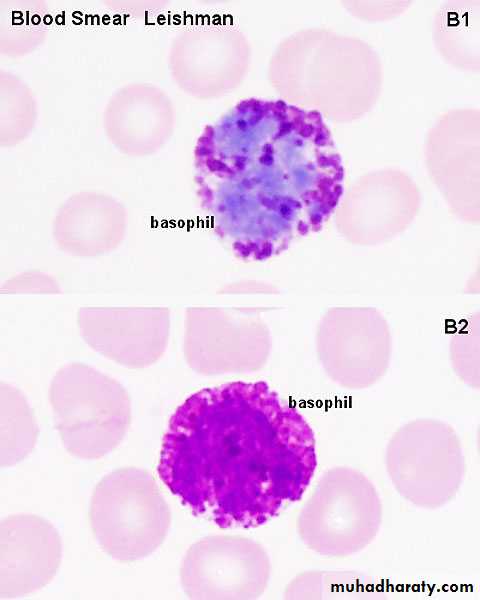

The Circulatory SystemDr. Eman ghanim
Large artary (aorta) characterize by :1-TM. Thick and consist mainly from many layer of elastic lamelea2-TA.not well developed and contain vasa vasorumElastic
Muscular artary characterize by:1- present of internal elastic lamina and external elastic lamena2-TM thich and consist of many layer of smooth m.Arterioles: 1- small 2- TM consist of 1-2 layer of SM
Capillaries : 1-TM replaced by pericytic cell2- no TA.
Type of capillary
vein medium size: 1- NO Internal nor external elastic lamina2- TA thick consist of collagen f. + longtudinal bundle of SM.
TM
MEDIAN SIZE VEIN
MEDIAN SIZE ART
VEIN AND ARTARY
VENA CAVA (LARGE VEIN: 1- TA well developed contain bundle of SM AND vasa vasorum2- TM not well developed . No elastic fiber .
sm
LARGE VEIN and LARGE ARTARY
Vena cavaaorta
Heart its wall consist of three tunics: internal: endocardium, middle: myocardium, external: epicardium
Purkinje fibers resemble ordinary cardiac m. in that:they have central nuclei.they have cross striation. However they differ from them in that
RBC: 1-These are rounded biconcave disks, bright red in color due to the presence of hemoglobin2- RBCs have no nuclei.
LM
EM
NEUTROPHIL : 1- nucl. is 3- lobes. 2- cytopl. Final granullymphocyte : 1- nucl. Oval –kidney shape 2- narrow rim cytopmonocyte : 1-. kidney shape nucl.2- clear large cytopl.
Eosinophil : 1- bilobed nucl.2- esonophil cytopl. Granulebasophil :1-basophil corse granule